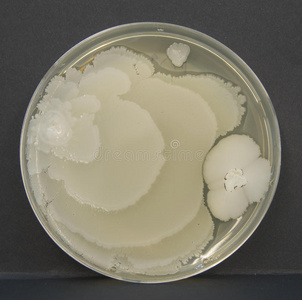
地衣芽孢杆菌图片

地衣芽孢杆菌

地衣芽孢杆菌在动物饲料中的作用_手机搜狐网
图片尺寸1000x750
地衣芽孢杆菌的介绍
图片尺寸466x322
地衣芽孢杆菌
图片尺寸1077x1159
带你了解地衣芽孢杆菌
图片尺寸2976x3968
地衣芽孢杆菌
图片尺寸500x500
地衣芽孢杆菌的介绍
图片尺寸640x480
地衣芽孢杆菌.jpg
图片尺寸800x606
京常乐 京新 地衣芽孢杆菌活菌胶囊 0.25g*18粒 1盒
图片尺寸800x800
地衣芽孢杆菌的功效与用途
图片尺寸390x390
地衣芽孢杆菌
图片尺寸500x500
2000亿地衣芽孢杆菌
图片尺寸739x510
地衣芽孢杆菌
图片尺寸1920x1586
地衣芽孢杆菌(其他生物相关)
图片尺寸1024x768
枯草地衣芽孢杆菌提取 诚信为本 山东得和明兴贸易供应
图片尺寸400x320
一种饲用地衣芽孢杆菌及其应用的制作方法
图片尺寸1000x981
一种高产四甲基吡嗪的地衣芽孢杆菌及其分离培养方法和应用与流程
图片尺寸1000x990
怎么从形态上区分枯草芽孢杆菌和地衣芽孢杆菌
图片尺寸600x800
地衣形芽孢杆菌(其他生物相关)
图片尺寸1092x1098
地衣芽孢杆菌图片
图片尺寸302x300地衣芽孢杆菌
图片尺寸764x572
猜你喜欢:地衣芽孢杆菌的作用地衣芽孢杆菌菌落图片蜡样芽孢杆菌芽孢杆菌图片巨大芽孢杆菌图片芽孢杆菌菌落地衣芽孢杆菌对植物胶质芽孢杆菌枯草芽孢杆菌菌落特征地衣芽孢杆菌胶囊地衣芽孢杆菌活菌胶囊地衣芽孢杆菌活菌颗粒巨大芽孢杆菌地衣芽孢杆菌图片凝结芽孢杆菌地衣芽孢杆菌形态地衣芽孢杆菌菌落枯草芽孢杆菌胶冻样芽孢杆菌侧孢芽孢杆菌地衣芽孢杆菌活菌图片芽孢杆菌地衣芽孢坚强芽孢杆菌枯草芽孢杆菌菌落凝结芽孢杆菌活菌片贝莱斯芽孢杆菌纳豆芽孢杆菌炭疽芽孢杆菌苏云金芽孢杆菌张林亭画家乔榛 童自荣法主公三尊图片女生帅起来留园濠濮亭图片美女肌肉突然膨胀变大英国名胜古迹皮卡丘闪电动态壁纸特效强凉茶陈金凌个人简介小城谣吉他谱c调韩信的素描画